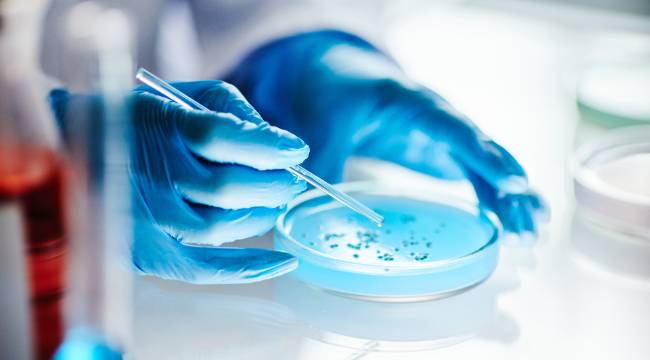

Son dönemde gündeme gelen uyuşturucu operasyonları, iş dünyasında da yeni bir süreci tetikledi. Daha önce yalnızca sürücülük, güvenlik ve ağır sanayi gibi sınırlı alanlarda talep edilen uyuşturucu madde testleri, artık birçok sektörde işe alım prosedürlerinin parçası haline gelmeye başladı.
sabah.com.tr'de yer alan habere göre, sağlık raporuna eklenen bu testler, bazı şirketlerde prosedürlere yazılı şart olarak dahil edilirken, bazı firmalarda mülakatın ilerleyen aşamalarında adaylara zorunlu kriter olarak sunuluyor. Laboratuvar firmaları ise söz konusu talebin 6-7 katına çıktığını ifade ediyor.
1 Laboratuvar şirketleri kurumsal paketler oluşturmaya başladı

İstanbul’da faaliyet gösteren bir laboratuvar şirketi, son aylarda işveren kaynaklı talebin belirgin biçimde yükseldiğini belirterek, laboratuvarların bu doğrultuda kurumsal paketler oluşturduğunu, toplu test anlaşmalarına yöneldiğini ve hızlı sonuç taahhüdü sunduğunu aktardı.
Ayrıca firmaların iş yerlerine mobil numune ekipleri göndermeye başladığı da ifade edildi.
2 İstanbul’da işveren talebiyle her gün 20 bini aşkın uyuşturucu tarama testi yapılıyor

İş dünyasında bu uygulama "Bağımlılık Yapıcı Madde Tarama Testi" adıyla biliniyor. Türkiye’nin önde gelen laboratuvarlarından birine gidilerek hem test örnekleri hem de analiz süreci yerinde incelendi. Yetkililerin aktardığına göre yalnızca İstanbul’da işveren talebiyle her gün 20 bini aşkın uyuşturucu tarama testi yapılıyor.
3 Rekabet belirgin biçimde arttı

Testlere yönelik hızlı artış, laboratuvar sektöründe rekabeti de belirgin biçimde artırdı. Çok sayıda laboratuvar çevrim içi reklamlarla üst sıralarda görünür olmayı hedeflerken, “uyuşturucu madde testi SGK’lıya indirim fırsatı” başlıklı ilanlar gelinen noktayı gözler önüne serdi.
4 Birçok kritik sektörde yaygınlaştı
Madde tarama testlerinin enerji, sanayi, lojistik, savunma, kimya ve ağır sanayi başta olmak üzere birçok kritik sektörde yaygınlaştığı ifade ediliyor.
Türkiye’nin stratejik şirketlerinden Tüpraş’ın da stajyerler dahil tüm adaylar için bu testi zorunlu tuttuğu öğrenilirken, kurum yetkilileri söz konusu uygulamayı teyit etti. Öte yandan büyükşehir belediyelerine bağlı ulaşım kuruluşlarında da son yıllarda düzenli taramaların başladığı, son iki yılda bu nedenle yaklaşık 50 kişinin görevine son verildiği belirtiliyor.
5 Denetimler hem iş girişte hem mevcut personel için daha sistematik yürütülüyor

TCDD’nin de madde kullanımına yönelik kontrolleri işe alım kriterleri içinde öncelikli başlıklar arasına aldığı görülüyor. Savunma ve havacılık sanayii gibi kritik üretim alanlarında faaliyet gösteren ASELSAN, HAVELSAN, ROKETSAN ve TUSAŞ gibi kurumlarda ise çalışan ve üretim güvenliği kapsamında bu denetimlerin yeni yıl itibarıyla hem işe girişte hem de mevcut personel için daha sistematik yürütüldüğü ifade ediliyor.
Uygulamanın en hızlı yayıldığı sektörlerin başında güvenlik, sağlık, lojistik, enerji, ağır sanayi, savunma ve yazılım alanları yer alıyor.
6 Küçük bir dikkat kaybı ciddi iş kazalarına yol açabilir

Uzmanlara göre bu alanlarda çalışanların dikkat seviyesi ve karar alma kabiliyeti yalnızca şirket performansını değil, doğrudan insan hayatını, kamu güvenliğini ve veri bütünlüğünü etkiliyor. Sanayi tesislerinde makine operatörlerinin küçük bir dikkat kaybının ciddi iş kazalarına yol açabildiği, bilişim alanında çalışan bir personelin tek bir hatasının milyonlarca veriyi riske atabilir.
7 Hukuki olarak bir sakıncası var mı?

Hukuki açıdan değerlendirildiğinde işverenlerin adaylardan madde testi istemesi bütünüyle yasaklanmış bir uygulama değil. Ancak talebin işin niteliğiyle doğrudan bağlantılı olması, adayın açık rızasının alınması ve sonuçların gizli tutulması gerekiyor. Aksi halde keyfi test uygulamalarının özel hayatın gizliliği ve kişisel verilerin korunması bakımından sorun yaratabileceği belirtiliyor.
Hukukçular, işyerinde uyuşturucu kullanılması veya bulundurulmasının İş Kanunu’nun 25/II maddesi kapsamında ahlak ve iyi niyet kurallarına aykırılık sayıldığını ve bu durumda işverenin çalışanı tazminatsız şekilde işten çıkarabileceğini hatırlatıyor.
8 Test fiyatları ne kadar?

Laboratuvar kaynaklarının aktardığına göre madde testlerinin piyasa bedeli ortalama 2 bin 200 TL seviyesinde bulunuyor. Ancak büyük ölçekli firmaların toplu anlaşmalar yapması durumunda bu tutarın daha aşağı çekilebildiği belirtiliyor. Testler ise ağırlıklı olarak idrar, kan ve tükürük örnekleri üzerinden uygulanıyor.
Laboratuvarlar, KVKK hükümleri doğrultusunda test sonuçlarını yalnızca ilgili kişiye teslim ediyor. Sonuçların işverene aktarılabilmesi için kişinin açık onayının bulunması gerekiyor. Bu nedenle raporlar çoğunlukla kapalı zarf içinde kişiye veriliyor. Dijital ortamda ise sadece kişisel erişime açık şekilde paylaşılıyor.












